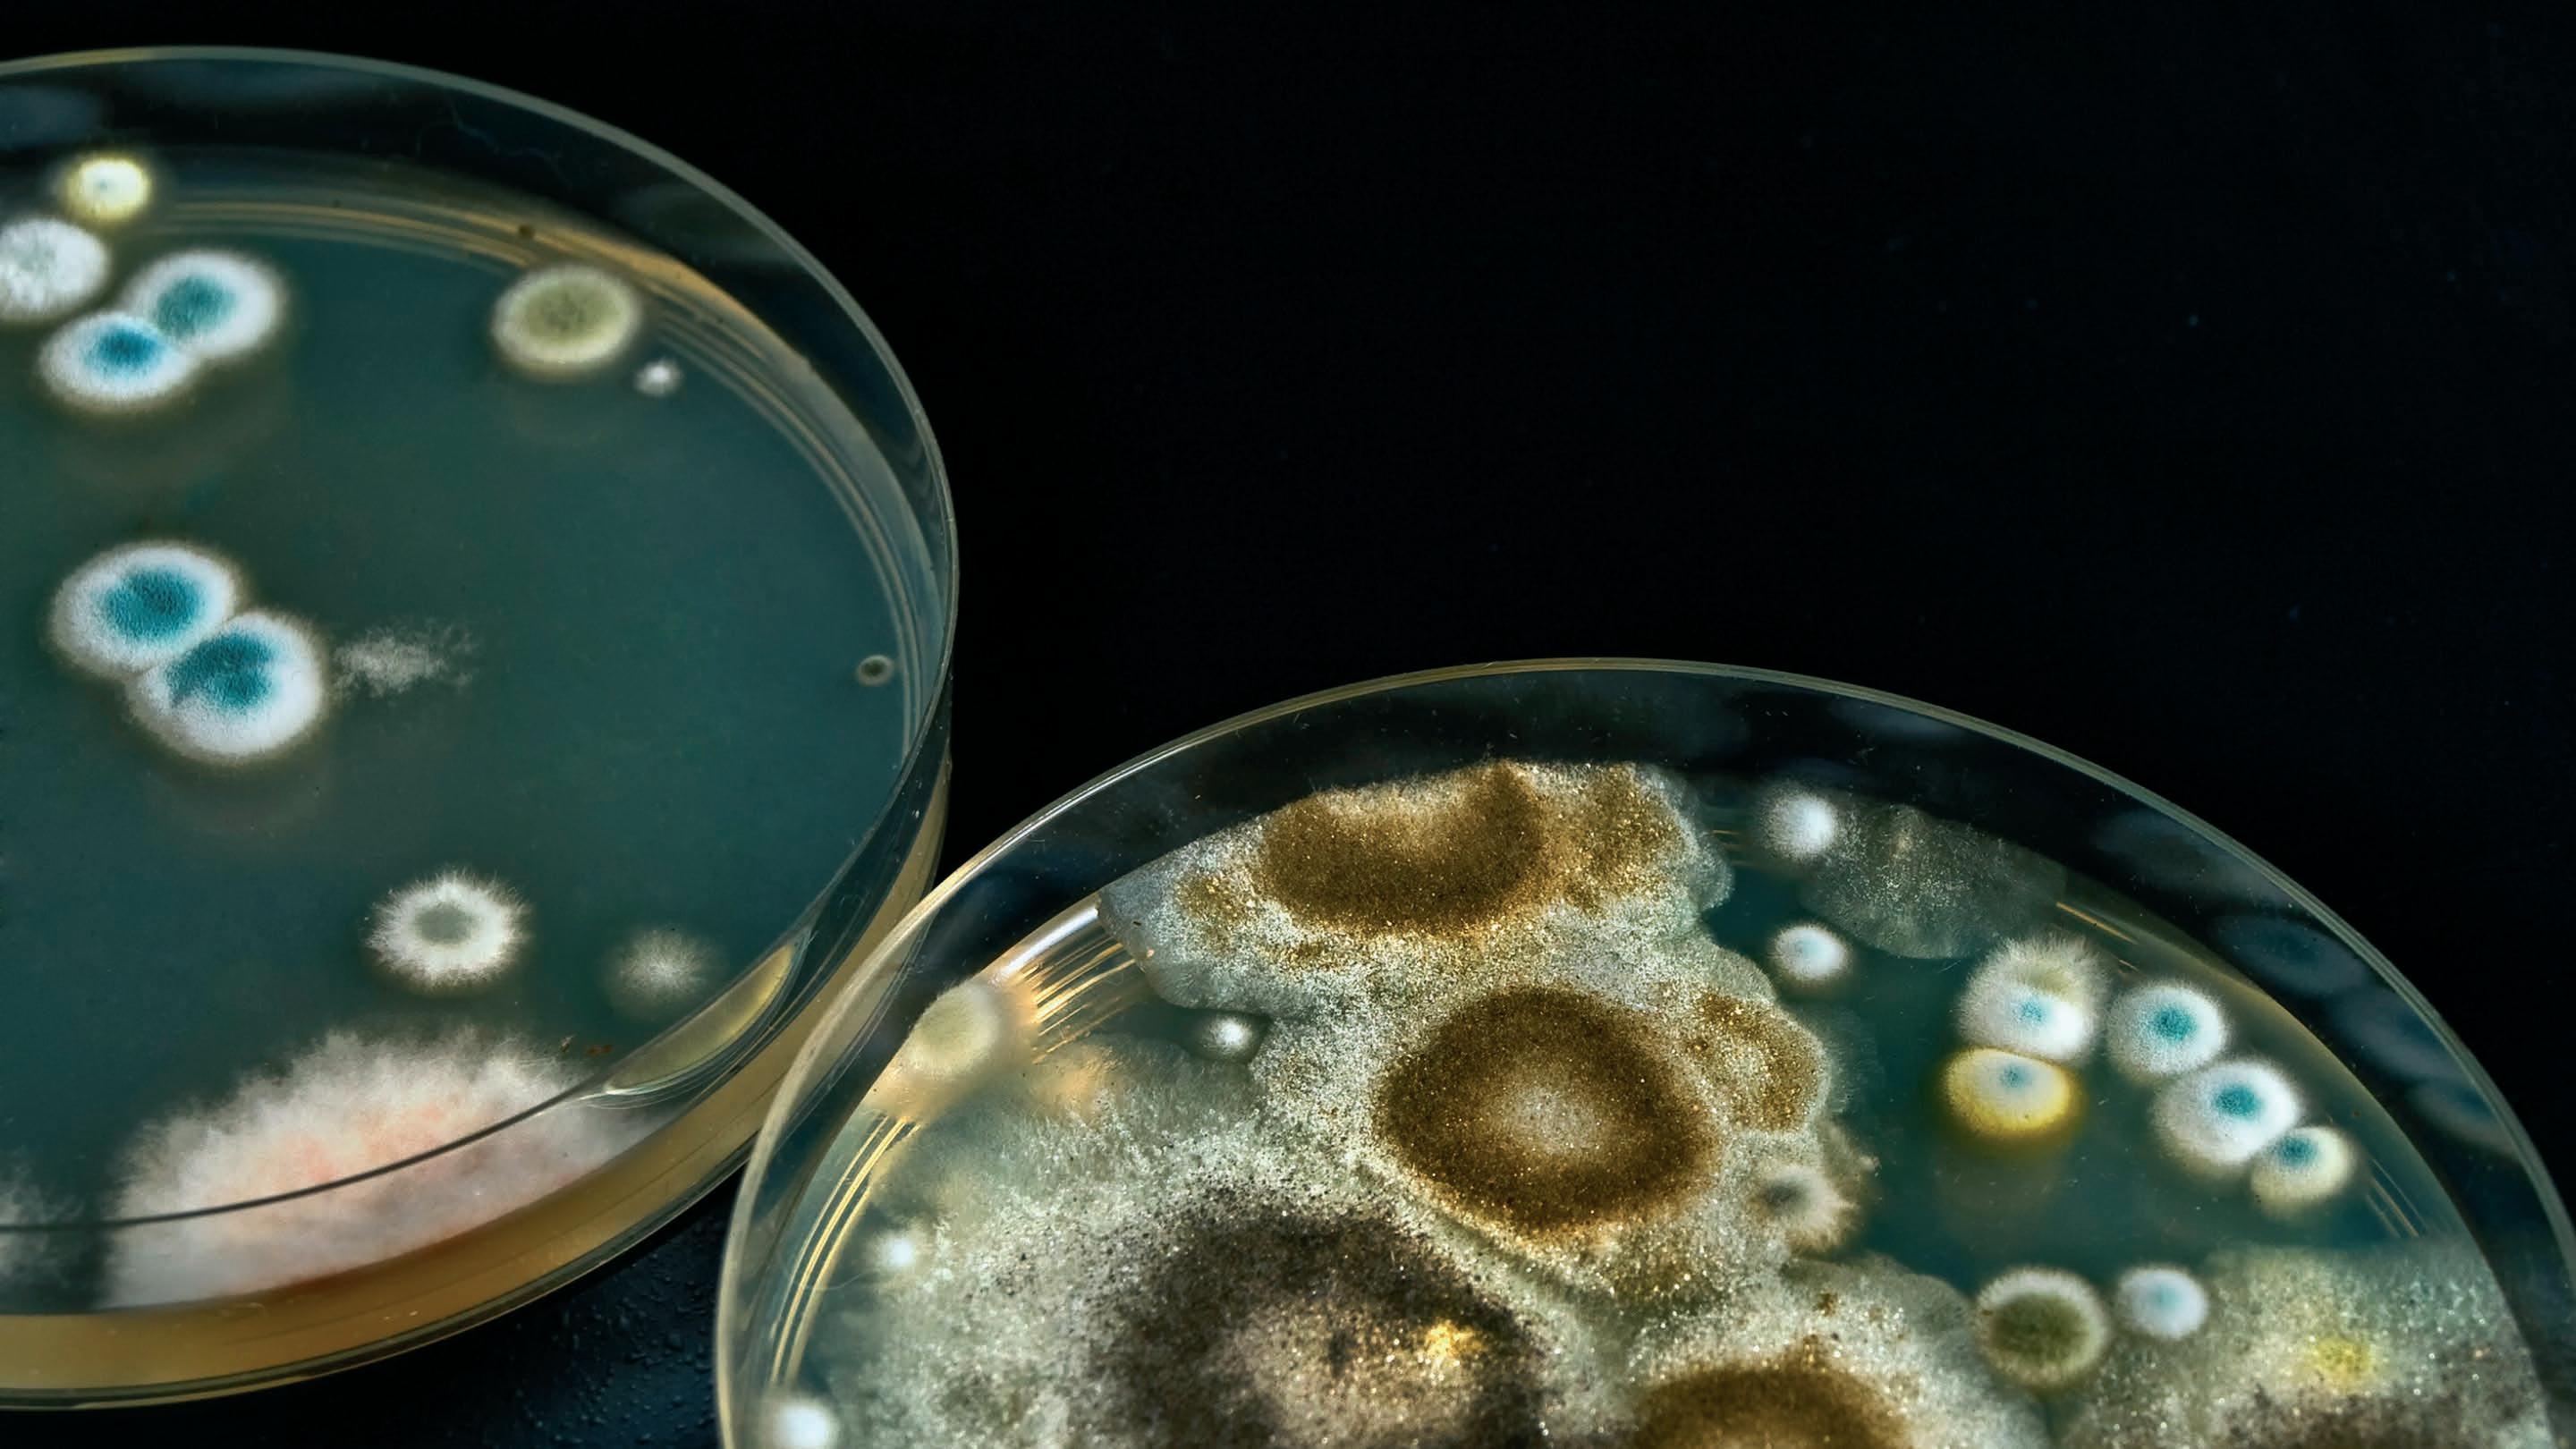

Revista de Controle Biológico


Manejo integrado de pragas: Conceitos, objetivos e bases
O MEP–MANEJO ECOLÓGICO DE PRAGAS NO AGRONEGÓCIO DE ALGODÃO

O alvo biológico e o sucesso da tecnologia de aplicação de bioinseticidas
O conhecimento do nível de controle de pragas é fundamental para a liberação de inimigos naturais

ANO 1 | n° 04 | Novembro de 2022
Distribuição gratuita
NORDESTE



INSCRIÇÕES PELO SITE: www.occasio.com.br 09.03.2023 8H HOTEL RITZ LAGOA DA ANTA - MACEIÓ O MAIOR EVENTO DE CONTROLE BIOLÓGICO EM CANA-DE-AÇÚCAR AGORA NO NORDESTE.
Editorial
O uso de bioinsumos tem aumentado nas culturas da cana-de-açúcar, milho e soja. São mais de 50 milhões de hectares que começam a desbravar novas fronteiras do conhecimento humano, no Brasil, e que nos coloca na vanguarda da produção agrícola mundial.
Nunca houve tanto respeito a Natureza quanto agora, nem tanto zelo com a qualidade dos nossos alimentos e com a saúde humana e animal. E essas melhorias ampliam o uso de bioinsumos para etapas agrícolas não exploradas, como a semeadura ou plantio, maturação e colheita, pós-colheita, como a preservação de frutos, e ambientes urbanos, como o controle de carrapatos em áreas infestadas.

Os conhecimentos básicos do controle biológico de pragas, doenças e plantas daninhas serão aprofundados nessa revista, assim como assuntos periféricos e ligados a essa nova realidade.
Novas máquinas e metodologias serão necessárias para que o uso de bioinsumos seja cada vez mais explorado e cada vez mais consciente. Manejar bioinsumos requer tecnologia e poder de decisão bem apurados.
Aproveitem essa edição e que ela os inspire!
Alexandre de Sene Pinto Editor
Gebio Revista de Controle Biológico
Novembro de 2022 ANO 1 . NÚMERO 4
EDITOR
Alexandre de Sene Pinto alexandre@occasio.com.br
ADMINISTRAÇÃO
Fabio Bueno fabio@occasio.com.br
VENDAS DE PUBLICIDADE
Ligia Rizzo gebio@occasio.com.br
PROJETO E ARTE-FINALIZAÇÃO
Senha Assessoria em Comuninação sac@senhaonline.com.br
Diagramação
Rodrigo Ferreira Iwahashi
FOTO DA CAPA: Shutterstock
GRÁFICA
Grupo Saint Edwiges de Artes Gráficas
OCCASIO editora e análises técnicas Ltda-ME
Rua do Trabalho, 396 Vila Independência, Piracicaba, SP 13.418-220
Distribuição Gratuita
Todo o conteúdo dos artigos é de responsabilidade dos autores que assinam.
Tiragem dessa edição: 2.000 exemplares Dúvidas, opiniões ou sugestões, escrever para contato@occasio.com.br
Quer anunciar?
gebio@occasio.com.br
Sumário
6
MANEJO
Manejo integrado de pragas: Conceitos, objetivos e bases
10
CAMPO
O alvo biológico e o sucesso da tecnologia de aplicação de bioinseticidas

29
NO CAMPO
Cana-de-açúcar: manejo de pragas de verão
CAMPO GRAVENA

O MEP–manejo ecológico de pragas no agronegócio de algodão



16

PESQUISA
Seletividade de inseticidas aos inimigos naturais: aplicações práticas para o MIP-Soja



36
PARRA FALA
O conhecimento do nível de controle de pragas é fundamental para a liberação de inimigos naturais
POLÉN
Polinização da soja 21
MANEJO INTEGRADO DE PRAGAS: CONCEITOS, OBJETIVOS E BASES
Pedro Takao Yamamoto, Fernando Henrique Iost Filho Departamento
Arelação dos insetos com as plantas já vem de longa data, mas o status de insetos-praga se iniciou após a domesticação das plantas, que representou o início da agricultura. Entretanto, nos primórdios da agricultura, as infestações catastróficas eram ausentes ou muito menos frequentes. Pode-se observar então que o conceito de praga está relacionado à competição pela pro-

dução agrícola.
Milhares de anos depois, o aumento no número de insetos-pragas foi mais frequente após o início da utilização dos inseticidas sintéticos, cuja utilização se iniciou já durante a segunda grande guerra mundial e se intensificou no pós-guerra. Isso significa que os insetos não eram controlados antes do advento dos inseti-
cidas sintéticos? Não, os insetos eram controlados, mas, a intervenção era realizada com produtos inorgânicos, alguns deles apesar de muito tóxicos aos seres humanos, apresentavam baixo impacto no agroecossistema.
Com a intensificação do uso dos inseticidas que, incialmente, apresentavam excelentes resultados, começaram a aparecer os efeitos colaterais
6
Adobestock
de Entomologia e Acarologia ESALQ/USP, Piracicaba, SP
Manejo
indesejáveis, com perturbações tanto no ecossistema como no agroecossitema, resultando em aumento do custo de produção, do uso de inseticidas, dos impactos dos inseticidas e, principalmente, da quantidade de pragas na lavoura. Como perturbações no ecossistema, podem-se citar efeitos prejudiciais ao homem, inimigos naturais, peixes e outros animais e, resíduos nos alimentos, água e solo. Já como perturbações no agroecossistema, têm-se a resistência dos insetos aos inseticidas, ressurgência da praga alvo de controle e surtos de pragas secundárias.
Em função desses efeitos colaterais, principalmente aqueles relacionadas às perturbações no agroecossistema, começou-se a pensar em diferentes abordagens para o controle de pragas. Um dos primeiros conceitos integrava o controle biológico com o químico e foi chamado de controle integrado. Posteriormente, novos componentes e conceitos foram incorporados culminando com a formatação do manejo integrado de pragas (MIP).
O que é manejo integrado de pragas
Antes de dizer o que é MIP, é importante ressaltar o que não é MIP:
1. O MIP não é novo; há milênios, os agricultores vêm usando os conceitos de sucessão ecológica e aprenderam a manejar as pragas que fazem parte dessa sucessão. No entanto, programas científicos formais direcionados ao MIP foram idealizados nas últimas cinco décadas.
2. O MIP não pode ser implementado da noite para o dia, a menos que se adote a visão minimalista empregando as táticas e informações disponíveis e numa mentalidade de ‘coloque o show na estrada’.
3. MIP não é agricultura orgânica. Este é um ponto crítico.
4. O MIP não é uma fórmula para eli-
minar o uso de produtos fitossanitários.
5. O MIP não é um modelo de gestão, mas simplesmente fornece opções apropriadas às próprias escolhas do produtor.
6. Os programas de MIP não são genéricos, são, na verdade, específicos quanto à escala geográfica e temporal e, dentro e entre as estações.
Já que sabemos o que não é MIP, vamos entender então o que é MIP. O MIP foi uma resposta da comunidade científica aos problemas gerados pelo uso inadequado dos produtos fitossanitários na agricultura que causaram os efeitos colaterais indesejados comentados anteriormente. Vários são os conceitos de MIP, sendo que a maioria aborda pontos semelhantes como: utilização de todas as técnicas disponíveis dentro de um programa unificado, de forma har-
moniosa e integrativa, manutenção da população das pragas abaixo do Nível de Dano Econômico (NDE) e minimização dos efeitos colaterais deletérios ao meio ambiente, ressaltando-se que devem ser levados em conta critérios econômicos, ecológicos e sociais.
Segundo M. Kogan (1998), em artigo publicado no Annual Review of Entomology, “MIP é um sistema de apoio de decisões para a seleção e adoção de táticas de controle de pragas, usadas individualmente ou harmoniosamente de maneira coordenada em uma estratégia de manejo baseada em análises de custo e benefício, que levam em conta os interesses dos produtores, e impactos na sociedade e no meio ambiente”.
Os componentes do termo MIP são: Integração - uso harmonioso de múltiplos métodos para controle
7
Adobestock
Manejo
Manejo
de uma praga ou um complexo de pragas; Praga - um organismo detrimental para os homens, incluindo: invertebrados, vertebrados, plantas daninhas e patógenos; e Manejodecisões baseadas em princípios ecológicos e econômico e considerações sociais.
O MIP é uma abordagem de sistema para controle de pragas que utiliza todas as estratégias apropriadas para minimizar o impacto das pragas e, ao mesmo tempo, proteger o ambiente e proporcionar retorno econômico aceitável. Ou seja, é uma abordagem abrangente para controle de pragas que utiliza combinações de táticas para reduzir o número de pragas para níveis toleráveis, mantendo um ambiente de qualidade. Assim, MIP é uma combinação coordenada e compatível de táticas adequadas que, no contexto do ambiente associado e dinâmica populacional das pragas, resulta em população de pragas que não causam danos econômicos.

MIP tem uma ampla aplicação, integrando o manejo de todas as pragas, com enfoque holístico e bases ecológicas, passível de ser aplicado em qualquer ecossistema. Além disso, integra várias táticas de manejo (químico, biológico, cultural, mecânico) de várias pragas (insetos, ervas daninhas, agentes patogénicos das doenças, nematóides, vertebrados, etc). Ainda, em algumas situações, integra táticas de manejo de pragas numa base de área ampla (muitas situações de controle de pragas são mais aplicadas em larga escala ou base regional). Vale ressaltar que na definição clássica de MIP, o conceito de praga é amplo quanto aos organismos deletérios, no entanto, na nossa agricultura, esse conceito é mais comum para designar os insetos e ácaros.
Por fim, a filosofia do MIP contempla a redução das pragas para níveis toleráveis, não enfatiza a erradicação ou eliminação de pragas, incorpo-
rando a sustentabilidade econômica, incorporando também os conceitos de nível de dano econômico e nível de ação/controle e outros fatores importantes, como a manutenção da qualidade estética e preocupações ambientais e sociais.
Objetivos de um programa de MIP
Inúmero são os objetivos do MIP, dentre eles:
1. Otimizar os lucros, que a longo prazo traz inúmeros benefícios ao produtor. Contudo, mesmo no curto prazo é possível gerar economia ao produtor.
2. Manter ou preservar os recursos, tanto agrícolas como naturais.
3. Utilizar o controle biológico natural, conservando os inimigos naturais e aumentando a sua ação no controle de pragas agrícolas.
4. Reduzir a contaminação ambien-
tal, com destaque para preservação do solo, águas subterrâneas e superficiais, polinizadores, animais selvagens, espécie em vias de extinção.
5. Usar racionalmente os produtos fitossanitários, e, com o uso daqueles seletivos e no momento adequado, manter os recursos naturais.
6. Minimizar problemas de resistência aos produtos fitossanitários.
7. Minimizar a ressurgência das pragas alvo de controle e surtos de pragas secundárias (muitas vezes causada pela eliminação de inimigos naturais com produtos fitossanitários utilizados de maneira inadequada).
8. Reduzir os resíduos de produtos fitossanitários em alimentos –manter a segurança alimentar.
9. Adotar táticas de manejo de pragas que são seguras para os trabalhadores rurais.
8
Adobestock
Passos chaves de um programa de MIP
O primeiro passo para implementar um programa de MIP é conhecer os problemas de pragas que afetam a sanidade das plantas. Outro ponto chave é determinar quanto de dano, causados por pragas, será inaceitável para cada situação. Na sequência, deve-se buscar e considerar todas as práticas (ferramentas ou táticas) disponíveis para o manejo de cada praga que ocorre na cultura e, integrar essas práticas de forma a tornar o controle mais sustentável e mais eficaz. Finalmente, outro passo chave é controlar as pragas levando-se em consideração “janelas de oportunidade”, ou seja, pontos no ciclo de vida das pragas quando elas são mais suscetíveis às ferramentas de controle.
Bases para o manejo integrado de pragas
A melhor representação do MIP é uma casa, onde temos o alicerce, pilares e telhado. Como base no MIP, um dos principais conhecimentos necessários é a correta identificação das pragas (taxonomia), que pode levar a um controle mais eficiente.

Além disso, deve se conhecer as fer-
ramentas disponíveis para monitorar as pragas e definir o momento de tomada de decisão, definido pelo nível de controle ou ação, dois componentes importantes das bases do MIP.
Para um eficiente manejo das pragas, também deve-se conhecer a influência dos fatores climáticos nas pragas e seus inimigos naturais, que pode evitar ou postergar uma medida de manejo. Além disso, conhecer os fatores naturais de mortalidade no agroecossistema também é importante, por exemplo o controle biológico natural exercido pelos inimigos naturais que ocorrem nesse ambiente.
Métodos de controle ou ferramentas do MIP
Como alicerces, temos os métodos ou ferramentas do MIP, que também são chamados de táticas. A maioria dessas ferramentas são direcionadas ao controle da praga, atuando diretamente na redução de sua população e, consequentemente, dos danos e prejuízos causados pelas pragas. Outras ferramentas são direcionadas à cultura, tornando-a menos atrativa e menos suscetível às pragas e, também, mais atrativas aos inimigos na-
turais. Essas ferramentas serão, posteriormente, abordadas e discutidas.
Consideração final
Apesar da filosofia do manejo integrado de pragas (MIP) não ser recente, a sua utilização ainda é restrita. A falta de conhecimento é um dos maiores fatores limitantes para adoção e implementação do MIP. Devido à falta de conhecimento, assume-se que o MIP é complicado, difícil de implementar e pode levar a perdas econômicas. Outro aspecto que pode reduzir e desacelerar a adoção do MIP é a falta de ferramentas para o controle das pragas. Contudo, esse ponto vem sendo sanado e diferentes opções de ferramentas têm sido estudadas e disponibilizadas para manejo de diferentes pragas em diferentes culturas, destacando-se a ampliação de ferramentas comerciais para o controle biológico. Dessa forma, podemos dizer que a perspectiva de aumento da adoção do MIP é muito boa, indo ao encontro de uma produção agrícola mais sustentável e regenerativa, cada vez mais desejada tanto pelos produtores, quanto pelos consumidores.
9 Manejo
Adobestock
O ALVO BIOLÓGICO E O SUCESSO DA TECNOLOGIA DE APLICAÇÃO DE BIOINSETICIDAS

10
Campo
Por Ricardo Polanczyk
Departamento de Fitossanidade, FCAV, Unesp, Jaboticabal, SP
Adobestock
Introdução
Embora a agricultura intensa visando à produção de commodities tenha menos de 100 anos, várias foram as estratégias utilizadas neste período no controle de pragas agrícolas. Todas, sem exceção, utilizaram a tecnologia mais moderna no momento, por exemplo, DDT e plantas transgênicas. De fato, prometiam “livrar” os agricultores das pragas rapidamente, com máxima eficiência e baixo custo.
O cenário do século 21 evidencia que o uso dessas, e outras estratégias, precisa ser revisto e otimizado. Apesar dos seus inúmeros benefícios, são crescentes e constantes os relatos de resistência das pragas aos agrotóxicos e plantas Bt, o que, muitas vezes, resulta em aumento da dose e do número de aplicações. A preocupação crescente da sociedade, a respeito dos resíduos de agrotóxicos no ambiente e nos alimentos, e seus impactos nos serviços do ecossistema (polinizadores e inimigos naturais) tem incrementado o debate sobre o
manejo agrícola mais sustentável.
Os agentes de controle biológico de pragas, sejam macro (parasitoides e predadores) ou microrganismos (fungos, vírus, bactérias e nematoides) são importantes pilares dessa sustentabilidade. Embora o primeiro caso mundial de sucesso do controle biológico data de 1888, com a importação de uma joaninha pelos EUA para controle de pragas em citros, no Brasil, somente na última década, casos de sucesso, como a startup BUG e o uso de bioinseticidas Bt contra Helicoverpa armigera, demonstraram que o comércio desses agentes de controle pode ser uma atividade empresarial sustentável e lucrativa.
Desde então, o número de empresas que produzem agentes de controle biológico vem crescendo de forma exponencial no Brasil. Grande parte deste aumento tem como fatores determinantes o baixo custo de desenvolvimento e evolução da resistência bem mais lenta em comparação aos inseticidas convencionais e plantas
Bt. Entretanto, vários desafios se fazem presentes para que o seu sucesso seja alcançado e consolidado, entre eles: melhoria nas formulações, avaliação da compatibilidade com agrotóxicos e, especialmente, a tecnologia e a aplicação.
Historicamente, no Brasil, o conhecimento do alvo biológico, ou seja, o inseto ou acaro-praga a ser controlado, tem sido desprezado em detrimento do marketing estruturado somente para o produto comercializado. Insetos possuem uma grande variabilidade genética e capacidade adaptativa, resultado de 300 milhões de anos de evolução, que resultaram na sua sobrevivência e condução ao status de maior grupo conhecido de espécies do planeta.
Isto posto, o presente artigo descreve a importância de conhecer o alvo da aplicação em termos biológicos, ecológicos e comportamentais, de forma que estas informações possam ser incorporadas à tecnologia de aplicação para maximizar o potencial

11
Campo
Adobestock
Campo
de controle dos bioinseticidas. Essa estratégia é essencial para que os referidos produtos possam ser considerados um dos pilares do manejo sustentável de pragas.
Taxonomia: O caso de Helicoverpa armigera
A predominância do uso de inseticidas de amplo espectro e plantas transgênicas no controle das pragas levou à simplificação das atividades agrícolas e, por consequência, as premissas do manejo integrado de pragas, especialmente, a identificação das pragas e seu monitoramento foram relegados a um segundo plano, principalmente, devido ao seu custo e dificuldades operacionais.
Entretanto, essa situação “confortável” não perdurou devido à complexidade e instabilidade do agroecossistema. Surtos de Helicoverpa spp. foram relatados no cerrado brasileiro em 2012 e, posteriormente, em ou-

tras regiões do Brasil, com impressionantes perdas em torno de US$ 2 bilhões. Esses danos foram inicialmente atribuídos à Helicoverpa zea, praga muito comum na cultura do milho e, logo os agricultores começaram a utilizar inseticidas registrados para esta praga. Entretanto, o insucesso na adoção destes produtos ficou evidente quando novos surtos foram relatados em várias regiões do Brasil, no segundo semestre de 2013, embora as vendas de inseticidas tenham aumentado em cerca de 40% entre janeiro e julho de 2013.
Contudo, no início de 2013, pesquisadores da EMBRAPA coletaram esse inseto em várias localidades do Brasil e identificaram o inseto como Helicoverpa armigera, espécie que ainda não havia sido relatada no Brasil. Posteriormente, estudos demonstraram que a entrada desse inseto, no Brasil, ocorreu entre 2006 e 2008. A correta identificação da espécie foi primor-
dial para viabilizar o seu controle, pois, implicou na revisão dos métodos de manejo até então utilizados. Essa praga encontra-se hoje sob controle em todo Brasil.
Comportamento da praga
No posicionamento do produto biológico podem ser utilizadas informações sobre o inseto, como, por exemplo, o comportamento da espécie praga; a migração, ou mesmo, a movimentação na planta. Em estudo realizado por entomologistas da Universidade Federal de Santa Maria, foi demonstrado que o comportamento de lepidópteros-praga da soja, varia durante o período noturno e diurno. A lagarta falsa-medideira (Chrysodeixis includens) prefere permanecer na parte inferior da planta durante o dia (períodos mais quentes) e durante a noite, parte das lagartas do terço mediano migram para a parte superior da planta, devido às temperaturas mais amenas. A lagarta da soja (Anticarsia gemmatalis), por sua vez, prefere a parte mediana da planta, com maior parte dos espécimes localizados na parte superior durante o dia. Mas, a espécie que apresentou diferenças mais marcantes foi a Spodoptera eridania, com a maioria das lagartas preferindo a parte inferior da planta durante o dia, enquanto à noite, a maioria delas localiza-se no terço superior da planta.
As lagartas da parte superior são um alvo mais fácil de ser atingido do que as lagartas nas partes mais inferiores da planta. A movimentação das lagartas, neste caso C. includens e S. eridania, ao longo do dia, pode ser levada em conta para decidir o melhor momento da aplicação. Ademais, a pulverização noturna de bioinseticidas pode favorecer a sua eficiência, devido a temperaturas e umidades mais amenas em comparação às condições diurnas.
Os bioinseticidas são mais eficientes
12
Composição etária da praga
Adobestock
contra os primeiros instares larvais (1º e 2º) de lepidópteros praga, enquanto a partir do terceiro instar, a eficiência fica reduzida em mais de 50%. Em estudo realizado com H. armigera no Laboratório de Controle Microbiano de Artrópodes Praga da FCAV/UNESP foi demostrado que, lagartas de quinto instar (CL50 1.420 ng Cry1Ac/cm2 de dieta artificial) são 45 vezes menos suscetíveis que as de primeiro instar (CL50 31 ng Cry1Ac/ cm2 de dieta artificial). Posteriormente, outro trabalho demonstrou que, para C. includens essa diferença
foi ainda maior, cerca de 400 vezes.
Em termos práticos, uma lagarta grande (a partir do terceiro instar), tem maior chance de se recuperar da infecção por um entomopatogeno como Bacillus thuringiensis (Bt), por exemplo. Para isso, seu sistema imune inicia um processo para reparar o seu intestino médio (alvo do Bt), descartando as células mortas e produzindo células novas. A ingestão de uma quantidade maior de alimento é fundamental para esta recuperação, o que pode ser traduzido em maior consumo foliar em condições
Campo
de campo.
Exemplo de sucesso de monitoramento em soja
Os três aspectos acima mencionados: taxonomia, comportamento da praga e sua composição etária dependem diretamente do monitoramento para alcançar os seus objetivos. Embora oneroso e de difícil execução, existem exemplos onde ele pode ser utilizado com retorno econômico para o produtor.

13
A tese defendida em 2013 pelo Prof. Dr. Valmir Aita da UFSM concluiu
Adobestock
Campo
que, o monitoramento com malha amostral de 50 × 50m para lagartas desfolhadoras pode ter viabilidade financeira. De fato, essa amostragem demonstrou que a população mais elevada de lagartas era localizada, sendo desnecessária a aplicação de inseticidas em área total. Dessa forma, o maior custo da amostragem em malha foi compensado pela economia na aplicação de inseticidas em 57%.
Deve-se destacar que, o uso de veículos aéreos não tripulados e uso de armadilhas inteligentes no monitoramento das lavouras serão instrumen-
tos importantes que tornarão essa atividade possível em lavouras muito grandes ou de difícil acesso. A evolução dessas tecnologias nos próximos anos proporcionará um monitoramento mais detalhado em termos específicos, populacionais e comportamentais das pragas.
Considerações finais
Os cientistas têm acumulado informações preciosas para o manejo de pragas agrícolas, mas, na maioria das vezes, estas não chegam ao produtor. É preciso estreitar as relações entre os diferentes setores da ativi-

dade agrícola, para que a troca de informações possibilite otimizar o uso de táticas de controle de pragas. Deve-se ressaltar que essa não é uma necessidade exclusivamente brasileira, conforme demonstrou o artigo publicado na revista Biological Conservation (https://doi.org/10.1016/j.biocon.2021.109065). Neste trabalho, um grupo de pesquisadores entrevistou cerca de 300 agricultores e cientistas na Alemanha e Áustria. Os autores enfatizaram a necessidade urgente de estreitar o diálogo entre cientistas, agricultores e empresas no que se refere às pesquisas, práticas no campo e política agrícola.

14
Comportamento diário de Spodoptera eridania (Guedes et al., 2006 – Revista Plantio Direto)


SELETIVIDADE DE INSETICIDAS AOS INIMIGOS NATURAIS: APLICAÇÕES PRÁTICAS PARA O MIP-SOJA
Por Dr. Juliano Pazini Entomologista, coordenador de fitossanidade – SLC Agrícola S/A
Aconservação de inimigos naturais num agroecossistema é o principal promotor de equilíbrio populacional de artrópodes-praga em posição inferior do que prevaleceria na ausência destes agentes (Gravena, 1992). Portanto, o cultivo sustentável de soja é dependente de estratégias menos nocivas de manejo de pragas concebidas sob os preceitos do Manejo Integrado Pragas (MIP). Para isso, devem ser escolhidos produtos fitossanitários que aliem eficiência no controle do organismo-alvo com o mínimo impacto sobre os agentes de controle biológico (Carvalho et al., 2007).
Mediante a dinâmica de insetos e outras pragas na agricultura, aliada a frequente introdução de novos compostos químicos visando seu controle, em distintas concentrações e formulações, os agricultores precisam de informações completas sobre produtos fitossanitários, a exemplo da seletividade, a fim de ajustarem suas rotinas de MIP. Por exemplo, Corrêa-Ferreira et al. (2010) demonstraram o impacto de um piretroide não seletivo quando utilizado na primeira aplicação para o manejo de Anticarsia gemmatalis Hübner e Chrysodeixis includens (Walker) (Lepidoptera: Noctuidae) em soja. Observaram-se ressurgência e níveis populacionais mais elevados das lagartas, em comparação com áreas que utilizaram In-

Pesquisa 16
seticidas Reguladores de Crescimento (IRC) (diflubenzurom) e biológicos (baculovírus AgMNPV), que se mostraram eficientes no controle das lagartas, mas não causaram eliminação drástica de inimigos naturais.
Diante disso, estudos de seletividade de produtos fitossanitários sobre inimigos naturais devem ser constantemente realizados, de modo que as informações disponibilizadas possam servir na tomada de decisão quanto ao produto e ao modo a ser aplicado. Isso porque, dependendo da tática de aplicação, um produto nocivo pode classificar-se como ecologicamente seletivo (Bueno et al., 2012). Na prática, a seletividade obtida pela aplicação de um produto é uma combinação das diferenças fisiológicas e ecológicas presentes
entre os organismos alvo e não alvo, sendo ambas cruciais ao equilíbrio do agroecossistema.
Seletividade fisiológica (SF): refere-se ao produto químico e está relacionada à maior tolerância do inimigo natural em relação à praga, quando é submetido à ação direta de um produto fitossanitário específico. Evidencia-se por conta da diferenciação fisiológica existente entre pragas e indivíduos não alvos da aplicação.
Sabe-se que a obtenção da SF com inseticidas neurotóxicos, muito utilizados na soja, é reduzida. Isso foi observado em estudo de toxicidade diferencial de inseticidas sobre Euschistus heros (Fabricius) (Hemiptera: Pentatomidae) e o parasitoide de ovos Telenomus podisi Ashmead

(Hymenoptera: Platygastridae) (Pazini et al., 2019). Mesmo assim, alguns resultados apontaram a existência de mecanismos fisiológicos em predadores que conferiram maior tolerância à certos inseticidas neurotóxicos, como é o caso do ácaro-predador Neoseiulus californicus (McGregor) (Mesostigmata: Phytoseiidae), que se mostrou até 25 vezes menos suscetível do que Tetranychus urticae Koch (Trombidiformes: Tetranychidae) (Sato et al., 2002), e de Podisus maculiventris (Say) (Hemiptera: Pentatomidae), que mostrou semelhança com Euschistus servus (Say) (Hemiptera: Pentatomidae) quanto à suscetibilidade para alguns inseticidas (Tillman; Mullinix Júnior, 2004).
A SF pode ser atingida pela alteração de dosagens dos produtos fitossani-
Pesquisa 17
tários para permitir a sobrevivência e a reprodução de inimigos naturais. Por exemplo, a variação da concentração de campo mais alta para a mais baixa de clorfenapir, clorantraniliprole e lambda-cialotrina aumentou significativamente a sobrevivência de Eriopis conexa (Germar) (Coleoptera: Coccinellidae); o mesmo foi verificado com o uso de espinosade e lambda-cialotrina sobre larvas de Chrysoperla externa Hagen, (Neuroptera: Chrysopidae) e espinosade sobre Orius insidiosus (Say) (Hemiptera: Anthocoridae) e Podisus nigrispinus Dallas (Heteroptera: Pentatomidae) (Barros et al., 2018). Porém, essa manipulação deve ser feita com base em pesquisas que atestem o alcance de taxas satisfatórias de controle. Nesse sentido, aceita-se que o controle de 80% da população de pragas representa a melhor relação entre necessidade de controle da

praga e preservação de inimigos naturais. Além disso, o emprego de inseticidas que atuam no crescimento e desenvolvimento, no intestino médio e, em alguns casos, de Diamidas, Espinosinas, Oxadiazinas, Sulfoxaminas ou Pirróis pode permitir buscar a SF com manutenção real da sobrevivência de predadores, como será ainda destacado nesse capítulo.
Seletividade ecológica (SE): consiste em realizar uma aplicação de modo que reduza o contato entre o produto e o inimigo natural, mas que controle satisfatoriamente os organismos alvo. A SE considera as diferenças de comportamento ou hábitat existentes entre pragas e inimigos naturais, podendo ocorrer no tempo ou espaço.
Segundo exemplos práticos, na soja, a SE pode ser alcançada em função da tática de aplicação do produto.
O comportamento espacial dos percevejos-da-soja de se concentrarem próximos às bordas da lavoura (Roggia, 2009) pode ser explorado como uma tática de controle localizada, com aplicações de inseticidas em bordadura para reduzir e/ou retardar o pico populacional dos percevejos, ao mesmo tempo que mantém refúgio para os inimigos naturais no restante da área. Pulverizações sobre reboleiras de ácaros e besouros desfolhadores, no início da infestação, também propiciam a SE. Bueno et al. (2012) comentam que o tratamento de sementes em substituição ao uso de inseticidas junto à dessecação é exemplo satisfatório de SE em soja, já que os produtos controlam as pragas iniciais, preservando os inimigos naturais que não ficam tão expostos aos inseticidas como ocorre nos métodos convencionais de aplicação. Gontijo et al. (2018) avaliaram o impacto
18
Pesquisa
do tratamento de sementes de soja com clorantraniliprole e tiametoxam sobre P. nigrispinus. Não foi observado mortalidade dos predadores no tratamento com clorantraniliprole e, mesmo que tiametoxam tenha causado 50% de mortalidade, esse índice é muito menor quando comparado com exposições diretas (Torres et al., 2002; Barros et al., 2018).
Entende-se que nenhuma ação, relativa à conservação de inimigos naturais em um programa de MIP, poderá ser implementada se não estiver acompanhada de outra ação que trate da seletividade de produtos fitossanitários ou da aplicação seletiva quando produtos não seletivos são a única opção viável. Para isso, pesquisas que objetivam conhecer o grau de impacto de produtos fitossanitários sobre inimigos naturais já vêm sendo realizadas em vários países, há
muitos anos. O grau de seletividade, que se baseia na mortalidade e na redução da capacidade benéfica do inimigo natural (oviposição, parasitismo ou predação e alterações populacionais), é variável, o que significa que os produtos não são classificados apenas como inócuos ou nocivos. Pesquisadores da “International Organization for Biological and Integrated Control of Noxious Animals and Plants” (IOBC) criaram metodologia padronizada de testes de seletividade, em laboratório, semicampo e campo, para classificar os produtos fitossanitários em classes de toxicidade que variam de 1 (inócuos) a 4 (nocivos) (Hassan, 1997), com vistas à indicação de produtos mais seletivos.
No Brasil, Torres e Bueno (2018) apresentaram relevantes resultados quanto aos benefícios da adoção de produtos fitossanitários seletivos
em um programa de MIP-Soja, com destaque não somente para redução do volume aplicado de inseticidas e preservação de inimigos naturais, mas também para ganhos absolutos de rentabilidade. Com isso, evidencia-se a necessidade de planejar a escolha dos produtos fitossanitários para o manejo de artrópodes-praga da soja de modo que torne o agroecossistema mais favorável à ação dos inimigos naturais. Assim, disponibilizou-se, aqui, opções de ingredientes ativos seletivos aos principais inimigos naturais que habitam o agroecossistema da soja, comprovados mediante consulta em literatura científica, sendo esses ingredientes ativos classificados pela IOBC como inócuos ou levemente nocivos sobre artrópodes predadores, como coccinelídeos, forficulídeos, antocorídeos, geocorídeos, pentatomídeos e fitoseídeos (Tabela 1).
Tabela 1. Opções de ingredientes ativos registrados para uso contra artrópodes-praga da soja no Brasil visando atingir seletividade fisiológica (SF) sobre espécies de predadores*. Adaptado de Torres; Bueno (2018).
Organismo-alvo
Lagartas2
Seleção de i.a.1
Primeira opção Segunda opção
ciantraniliprole; clorantraniliprole; diflubenzurom; flubendiamida; formulações de Bacillus thuringiensis; formulações de baculovírus; lufenurom; metoxifenozida; tebufenozida; teflubenzurom; triflumurom
clorfenapir; espinetoram; espinosade; indoxacarbe; metaflumizone
Percevejos3 etofenproxi**;
Mosca-branca4
Ácaros5
Tripes6
buprofezina; ciantraniliprole; espiromesifeno; piriproxifem
acetamiprido; sulfoxaflor
azadiractina; espiromesifeno abamectina; diafentiurom; propargito
1Recomendação de ingredientes ativos em primeira e segunda opções (em ordem alfabética) para uso visando a preservação de espécies de predadores comumente encontrados no agroecossistema da soja, mediante literatura científica consultada que empregou a classificação da IOBC. 2Lagartas: Anticarsia gemmatalis, Chloridea virescens, Chrysodeixis includens, Helicoverpa armigera, Rachiplusia nu, Spodoptera cosmioides, Spodoptera eridania, Spodoptera frugiperda, Trichoplusia ni 3Percevejos: Diceraeus melacanthus, Euschistus heros, Nezara viridula, Piezodorus guildinii 4Mosca-branca: Bemisia tabaci biótipo B. 5Ácaros: Mononychellus planki, Tetranychus urticae 6Tripes: Caliothrips brasiliensis, Caliothrips phaseoli, Frankliniella rodeos, Frankliniella schultzei. *Predadores: Doru lineare, D. luteipes, Eriopis conexa, Geocoris spp., Hippodamia convergens, Neoseiulus californicus, Orius insidiosus, Phytoseiulus macropilis, Podisus nigrispinus **Informações no corpo do texto. – Sem opção seletiva.
Pesquisa 19
Nas últimas duas décadas, uma preocupação têm sido os efeitos adversos de produtos fitossanitários sobre a saúde e o meio ambiente, o que tem direcionado o desenvolvimento de moléculas com maior seletividade aos organismos não-alvo (Omoto, 2000). Nesse sentido, os IRC têm apresentado maior seletividade sobre agentes de controle biológico, como os predadores (Tabela 1). Esses inseticidas mostram-se boas opções para uso, desde a fase vegetativa, no manejo de moscas-brancas e de lagartas - principalmente em ínstares iniciais - que não são controladas pela soja Bt. Diamidas, Espinosinas, Oxadiazinas, Sulfoxaminas, Pirróis e formulações de Bacillus thuringiensis (Bt) e de vírus de poliedrose nuclear (baculovírus) também têm aliado eficiência de controle de lepidópteros-praga da soja e seletividade aos principais predadores (Tabela 1). Essas características os classificam como as primeiras opções para uso em MIP-Soja em alternativa aos inseticidas tradicionais, como organofosforados, carbamatos e piretroides.
O manejo de pragas com inseticidas seletivos, na fase vegetativa da soja, como lagartas e moscas-brancas, interfere na dinâmica populacional de outras pragas ao longo da cultura; o uso de inseticidas pouco seletivos nessa época pode desfavorecer os inimigos naturais e favorecer o crescimento populacional dos percevejos-praga na fase reprodutiva (Roggia et al., 2011). No entanto, é importante comentar que, apesar da maior seletividade dos IRC, Diamidas, Espinosinas, Oxadiazinas, Sulfoxaminas, Pirróis e formulações a base de Bt e de baculovírus aos agentes de biocontrole, há alguns trabalhos que relataram, por exemplo, efeitos nocivos dos IRC, letais sobre a fase imatura (Stecca et al., 2017) e subletais sobre a fase adulta de predadores (Godoy et al., 2004). Isso evidencia que qualquer composto químico, mesmo os mais seletivos, deve ser utilizado somente quando os níveis de controle das pragas fo-
rem atingidos mediante constatação por monitoramento.
O maior entrave para o alcance da SF sobre os predadores encontra-se no manejo químico de percevejos e tripes. Atualmente, nenhum ingrediente ativo registrado para essas pragas (Brasil, 2020) é fisiologicamente seletivo (Tabela 1). Essa dificuldade é acentuada para o controle de percevejos, já que as formulações disponíveis apresentam amplo espectro de ação, geralmente composta de Neonicotinoide + Piretroide (mistura). Com base na literatura, etofenproxi (**Tabela 1) tem sido classificado de modo variável, de levemente a moderadamente nocivo à diferentes espécies de predadores. Porém, devido a importância econômica do percevejo-verde-pequeno Piezodorus guildinii (Westwood) (Hemiptera: Pentatomidae), acrescentou-se esse inseticida como opção para uso por ser menos nocivo à entomofauna benéfica em testes de seletividade (Redoan et al., 2013; Pasini et al., 2018), quando comparados a outros piretroides. De qualquer modo, a ausência de produtos fitossanitários com capacidade de promover SF à comunidade de predadores pode ser reparada por meio de táticas de aplicação seletiva de produtos não seletivos,
conforme já demonstrado por exemplos práticos para aumento da SE. Portanto, para que seja possível reduzir os impactos de produtos fitossanitários sobre os agentes de controle biológico natural de artrópodes-praga da soja é fundamental que agricultores e técnicos extensionistas adotem os preceitos do MIP quanto à escolha de produtos seletivos ou de táticas de aplicação que minimizem a exposição dos inimigos naturais ao produto não seletivo aplicado nas lavouras. Diante do exposto e frente ao intenso desenvolvimento e comercialização de novos compostos inseticidas, bem como as exigências de mercados consumidores, tornam-se necessários estudos frequentes sobre o impacto de produtos fitossanitários sobre a comunidade de predadores da soja, aliada a divulgação acessível dessas informações, de modo que se aprofunde o conhecimento de como obter a plena compatibilização do controle químico com o controle biológico nas suas diferentes formas (Gravena, 1992), num sistema de produção ainda totalmente dependente do emprego de ferramentas químicas de controle de artrópodes-praga, como é a soja no Brasil.

20
Pesquisa
POLINIZAÇÃO DA SOJA
Por Darclet Teresinha Malerbo-Souza,
Carlos Silva Pimen-
Os insetos são os responsáveis pela polinização de grande número de plantas e algumas espécies, sem a presença deles, correriam o risco de não produzirem e até de se extinguirem. O conhecimento da relação inseto-planta é um passo importante para a preservação da entomofauna em ecossistemas naturais, urbanos e, principalmente, agrícolas já que muitas vezes, a presença de agentes polinizadores aumenta a produção de grãos, frutos e sementes. Entretanto, as abelhas correm grande risco diante dos agrotóxicos utilizados na agricultura.
A eficiência da polinização, por qualquer agente biológico, está intimamente relacionada com a biologia floral da planta e o comportamento forrageiro do animal. Desta forma, é de grande interesse que se conheçam as relações existentes entre a fenologia de uma determinada planta, seus agentes polinizadores e os resultados daí advindos, principalmente se o interesse for voltado para uma polinização comercial ou a produção de alimentos.
A polinização é o processo de transferência do pólen do estame para o pistilo das flores, que são órgãos reprodutivos das plantas. Em geral, as flores podem ser divididas em entomófilas: as flores atraem insetos para transferir o pólen para o pistilo da mesma flor, ou para outra flor da mesma espécie (polinização cruzada); anemófilas: onde o vento é o vetor que move pólen de uma flor para outra, ou dos estames para o pistilo da mesma flor. Nesse caso, não há

necessidade de atrair polinizadores e autopolinizadas: sendo que em algumas plantas, como a soja (Glycine max L. Merrill), a maioria das flores são autopolinizadas antes de as flores abrirem. Em outras plantas, as flores nunca abrem, mesmo depois de ocorrer a autopolinização. Estes dois tipos de flores são chamados de cleistogâmicas.
Entretanto, existem algumas evidências de que mesmo as plantas cleis-
togâmicas, como a soja, podem se beneficiar de polinização entomófila, incrementando a sua produtividade. Práticas na cultura, como a aplicação correta de agrotóxicos, promove o serviço ecossistêmico de polinização e protege a biodiversidade de polinizadores.
Dentre os diversos agentes polinizadores, os insetos parecem ser os mais importantes, particularmente devido ao grande número de espécies deste
21 Pólen
André
tel e Carlos Frederico Silva da Costa Setor de Apicultura e Meliponicultura, Departamento de Zootecnia, Universidade Federal Rural de Pernambuco, Recife, PE
Adobestock
grupo. Entre esses insetos, as abelhas exercem um importante papel, por alimentarem-se de pólen e néctar, fazendo visitas diárias às flores, buscando alimentos para si, para as crias e/ou para a colônia. A frequente visita das abelhas nas flores está relacionada à dependência dos recursos florais, desde a fase larval até a fase adulta, sendo o pólen a fonte proteica e o néctar a fonte energética. Entretanto, nem sempre as abelhas têm fontes de recursos alimentares, durante todo o ano.
As abelhas são, sem dúvida, os polinizadores mais importantes para a reprodução da maior parte das angiospermas, seja em ecossistemas naturais ou em plantios agrícolas, sendo o seu principal papel biológico. Por isso, cada vez mais, as abelhas são utilizadas na produção agrícola, tanto para aumento da produtividade quanto para melhorar a qualidade dos frutos.
A diversidade no grupo das abelhas e as adaptações morfológicas tanto nas estruturas de coleta quanto nas de transporte, fisiológicas, e comportamentais otimizam a localização e a exploração dos recursos florais. Acredita-se que abelhas e angiospermas coevoluíram mutuamente ao longo do tempo evolutivo, beneficiando os dois grupos envolvidos. Temos mais de vinte mil espécies de abelhas catalogadas e a cada período novas espécies vêm sendo descobertas.
Ao mesmo tempo, conhecer o período de floração de cada planta, ao redor de apiários e meliponários, durante o ano, possibilita introduzir espécies vegetais que floresçam e forneçam néctar e pólen às abelhas, nas épocas de escassez de recursos florais (MALERBO-SOUZA et al., 2008).

O período de floração, a produção de néctar e pólen, odor e outras características são variáveis de atração de determinados grupos de polinizadores. O néctar é, muitas vezes, a única fonte energética para atividade me-
tabólica de seus polinizadores, sendo que a planta gasta parte da sua energia na produção de néctar como atrativo para os visitantes florais.
Dentre as espécies vegetais que as abelhas visitam, as flores da soja têm grande importância, principalmente, nas grandes áreas produtoras desse grão, muitas vezes sendo o alimento exclusivo. A soja ocupa o primeiro lugar em consumo dentre as leguminosas alimentícias, sendo utilizada de várias formas na alimentação humana. É, ainda, importante como matéria prima para a produção de óleos, tortas para alimentação animal e fertilizantes. As pequenas flores da soja nascem em racemos de 3 a 15 flores, variando sua coloração de branca a púrpura, sendo que cada flor dá origem a uma vagem com 1 a 5 sementes.
A soja é uma planta herbácea, cultivada no Brasil, para a produção de grãos, pertencente à família Fabaceae, subfamília Faboideae. As flores são hermafroditas e lateralmente simétricas com um cálice tubular de cinco sépalas verdes e pubescentes (Figuras 1 e 2). A corola é branca ou lilás pálida a roxa, com cinco pétalas.
A pétala posterior é a mais externa, as pétalas laterais com asas longas e as duas pétalas unidas anteriores formam uma quilha. O órgão feminino possui um carpelo com ovário alongado, superior, verde e unilocular. O estilete é longo, terminando no estigma. O órgão masculino é composto por nove estames fundidos em um tubo e um estame posterior livre.
As flores da soja, geralmente, se autopolinizam antes que as flores estejam completamente abertas. Por ocasião da polinização, os estames diadelfos (fundidos) elevam-se para que as anteras formem um anel ao redor do estigma. Assim, o pólen derrama-se, diretamente, sobre o estigma, resultando em elevada percentagem de autofecundação, a qual ocorre no dia imediatamente anterior à abertura total da flor. Estudos indicam que a polinização cruzada na soja se situa em torno de 2%, porém, valores maiores também têm sido observados.
A planta de soja é considerada cleistogâmica, ou seja, pertence ao grupo de plantas majoritariamente autopolinizadas. Entretanto, quando ocorre a polinização cruzada na cultura da soja, ela é mediada pelos polinizado-
22 Pólen
Figura 1. Estrutura de uma flor típica da família Fabaceae (Gazzoni, 2017)
res, especialmente, as abelhas.
Estudos com 17 cultivares de soja indicam que as flores permanecem abertas apenas por um dia e a secreção de néctar ocorre entre 9h e 15h. A produção de néctar por flor varia de 0,022 a 0,127 µL entre as cultivares, enquanto o conteúdo total de carboidratos no néctar varia de 0,301 a 1,354 µg/µL. Ocorre grande variação no conteúdo dos açúcares totais e individuais. O teor de carboidratos totais por flor varia de 16 a 134 µg, enquanto o conteúdo de frutose, glicose e sacarose varia de 42 a 314 µg/µL, de 43 a 262 µg/µL, e de 97 a 986 µg/µL, respectivamente. As proporções de frutose:glicose:sacarose entre as cultivares variaram amplamente, desde aquelas com baixo teor de sacarose até as que apresentaram alta proporção de sacarose.

As flores de soja têm um período curto de viabilidade para a polinização e fecundação, o que condiciona o forrageamento por abelhas, que é altamente correlacionado com a disponibilidade de pólen e néctar. Estudos observaram que o conteúdo de açúcar total no néctar de flores de soja variou de 37 a 45%, verificando aumento do teor de carboidratos e diminuição do volume de néctar de
acordo com a hora do dia e a temperatura. A hora do dia foi o principal fator a afetar as características do néctar de soja pois os teores de frutose, glicose, sacarose e o total de carboidratos no néctar aumentou ao longo do dia, enquanto o volume de néctar por flor diminuiu.
O néctar contém água, açúcares e aminoácidos para atrair polinizadores. Também são encontrados compostos secundários e proteínas antimicrobianas. Existem diferenças nas características do néctar entre as cultivares de soja, o que poderia estabelecer preferências de forrageamento pelas abelhas
A visita de uma abelha a uma flor envolve a orientação de uma distância relativamente grande até a proximidade da flor e a orientação a curta distância, quando a abelha pousa e prova o néctar. O aroma floral, a cor e a forma das flores influenciam não apenas a visitação inicial de abelhas, como fornecem pontos de referência que as abelhas utilizam para otimizar o forrageamento em uma espécie de planta específica, sendo a base da fidelização das abelhas a determinadas flores. No entanto, chegar à flor de determinada planta não é suficiente, a fidelidade a uma dada
espécie exige um reforço para a continuidade do forrageamento. No caso de grandes áreas de plantação de soja, a quantidade de flores que se abrem compensam as variações na concentração de açúcares e volume do néctar.
Existem registros de apicultores norte-americanos e brasileiros de que as abelhas produzem quantidades significativas de mel de soja, indicando forrageamento ativo e coleta de néctar e de pólen em flores de soja. Além disso, um estudo conduzido em Iowa, EUA, informou que 61 de 63 amostras de mel continham pólen de soja, o que indica que eles foram obtidos, pelo menos parcialmente (510%), a partir de soja.
Com relação à produção de mel nas plantações de soja, Aldo Machado dos Santos trabalha com apicultura em São Gabriel, no Rio Grande do Sul e relatou em “live” que tanto tempo de manejo de abelhas o fez aprovar um jeito de integrar a produção de mel com a produção de grãos de soja. Segundo ele, há certo preconceito no processo com a oleaginosa em razão do uso de agrotóxicos, mas garante que, se os químicos forem aplicados da forma correta, a lavoura pode ser rentável tanto para o produtor quanto para o apicultor. Ele relatou que no período em que a soja floresce, não tem outro tipo de florada na região, tendo que alimentar essas abelhas. Com o produtor utilizando os agroquímicos de forma correta, o apicultor começou não perder as abelhas e os enxames começaram a produzir mel, crescendo muito na época da soja, conta Machado. Em 2021, com cerca de 800 caixas, colheu mais de 23 toneladas de mel só na soja.
Ao longo dos últimos anos, os apicultores têm percebido que a soja pode ser um ótimo pasto apícola, afirma Décio Luiz Gazzoni, engenheiro agrônomo, autor do livro “Abelhas e Soja”, pesquisador da Embrapa e membro do comitê científico da Associação
23 Pólen
Figura 2. Representação esquemática da flor de soja, incluindo o nectário (Gazzoni, 2017).
Estudos mostram que a combinação de colônias da abelha melífera e a presença de abelhas silvestres nas plantações de soja aumenta o número de vagens por planta e sementes por vagem. A atratividade das flores para as abelhas é altamente dependente da variedade da soja. E existem muitas variedades de soja cultivadas no Brasil, sendo constantemente, melhoradas.

Várias espécies de abelhas foram observadas nas flores da soja, sendo a mais frequente e constante a abelha africanizada Apis mellifera Outras espécies como Tetragonisca sp., Trigona fuscipennis, Trigona sp., Bombus sp., Dialictus sp., Halictus sp., Exomalopsis spp., Augochlora sp., Megachile sp. e outras. Malerbo-Souza et al. (2003) estudando a var. Conquista, em Ribeirão Preto, SP, constataram que os insetos observados na soja foram abelhas africanizadas A. mellifera (84,93%), seguida de lepidópteros (5,75%), Diabrotica speciosa (2,74%), Lagria villosa (ColeopteraLagriidae) (2,47%), vespídeos (2,47%), Trigona spp. (0,82%) e outros (0,82%). Esses insetos coletaram exclusivamente néctar nas flores da soja.
Pode-se observar que existem diferenças de ano para ano dos visitantes florais na soja, mas, no geral, as abelhas africanizadas têm sido um visitante constante nessas flores, em diferentes localidades.
De acordo com alguns autores, as abelhas visitam as flores de soja tanto para a coleta de pólen como de néctar, sendo que a quantidade de néctar produzido por flor é pequena, mas como as áreas de cultivo são grandes, no final, representam uma quantidade alta coletada pelas abelhas.

A literatura aponta a soja como uma espécie autógama, cleistogâmica, fecundada por autopolinização. No
entanto, há controvérsias, sendo que determinados autores evidenciam que a soja poderia se beneficiar de polinização por insetos com aumento de rendimento.
A necessidade de polinização pela soja varia com o cultivar e as condições externas. As flores de alguns cultivares nunca abrem e somente a autopolinização é possível. As flores de outros cultivares só abrem em condições favoráveis; outras podem abrir em certas condições e não abrir em outras. Várias pesquisas foram realizadas para avaliar o efeito das visitas dos insetos na produção de vagens e grãos, em cultura de soja.
Alguns estudos mostraram que a polinização pelas abelhas africanizadas
A. mellifera aumenta a produção em alguns cultivares de soja. Autores encontraram que plantas em estufas contendo uma colônia de abelhas
Apis tiveram 22% mais sementes e 20% mais vagens com sementes que
plantas em estufas sem abelhas, entretanto, o peso das sementes não diferiu nas áreas com ou sem abelhas.
Estudos realizados em Piracicaba, SP, verificaram, no cultivar IAC-14, que o número de vagens/cova, de sementes/vagem e de sementes/cova foram 58,58%, 15,66% e 82,31% maiores, respectivamente, nas plantas com livre acesso dos insetos comparados à área telada. O número de vagens com três a quatro sementes também foi maior nas plantas visitadas por abelhas.
Em Jaboticabal, SP, estudo com a variedade FT 2000, obteve aumento de 30,07% no número de vagens, 29,80% na quantidade média de sementes por planta e 11,7% no peso de sementes por planta no tratamento descoberto comparado ao tratamento coberto, sem acesso das abelhas.
Em Maringá, PR, estudos relataram que a produção de grãos de soja foi maior no tratamento coberto com
24
Pólen
Brasileira de Estudo das Abelhas (A.B.E.L.H.A.).
Adobestock
abelhas (50,6%) e no tratamento descoberto (36,6%) que no tratamento coberto sem abelhas. Eles consideraram que as abelhas africanizadas foram responsáveis por 87,7% da polinização efetuada por insetos. Também o número de vagens no tratamento coberto com abelhas foi 61,38% maior que no coberto sem abelhas, reforçando a necessidade da presença das abelhas para o aumento da produção de grãos de soja.
Estudo em Ribeirão Preto, SP, autores observaram que o número de vagens por planta e o número de grãos por planta não apresentaram diferença
Literatura Consultada:
significativa nas áreas mantidas cobertas, sem acesso de insetos, e áreas descobertas, onde os insetos estavam presentes. O peso total dos grãos por planta foi significativamente maior (43,68%) na área onde foi permitida a visita dos insetos (23,695g, em média) do que na área coberta (16,491g, em média), onde essa visita foi impedida. O peso médio dos grãos também foi maior (50,12%) no tratamento descoberto (0,1797g) que no coberto (0,1197g). Os autores observaram que a área coberta, onde não houve visita dos insetos, houve maior número de vagens com apenas um grão. O contrário aconteceu nas flores visitadas
GAZZONI, D.L. Plantas que os polinizadores gostam. Brasília, DF: Embrapa, 2021 1016p.
GAZZONI, D.L. Abelhas e soja, Brasil, DF: EMBRAPA, 2017 151p.
MALERBO-SOUZA, D. T.; TOLEDO, V. A. A.; PINTO, A. S. Ecologia da polinização. Piracicaba: CP2, 2008.
por insetos, nestas flores houve maior número de vagens com dois ou três grãos. Esses dados demonstram que a presença dos insetos principalmente das abelhas africanizadas, aumentaram a granação das vagens, além disso, os grãos foram mais pesados. Entretanto, muitos estudos não constataram aumentos no número de vagens e grãos, e peso dos grãos com a presença dos agentes polinizadores.
Em conclusão, existem resultados conflitantes na literatura consultada, alguns autores relatando aumentos médios de 10 a 50% na produtividade da soja, quando as condições de polinização por insetos são adequadas, contrastando com a referência de que a polinização cruzada fica entre 0,3-3,5% das flores de soja, concordando com os autores que não verificaram aumento da produtividade da soja que pudesse ser atribuída à polinização entomófila.
De qualquer forma, em função de fatores adversos como a degradação de áreas vegetais e a implantação de monoculturas, as espécies e as famílias de abelhas tem entrado em declínio e a conservação desses importantes insetos depende da preservação da flora e alterações nos sistemas de produção. Por outro lado, houve crescimento no interesse dos agricultores familiares para a criação de abelhas, tanto as melíferas como as nativas sem ferrão, em função do valor econômico dos seus produtos, podendo ser uma fonte de renda importante para essas famílias, sendo que o mel da soja pode ser um deles.

MALERBO-SOUZA, D. T., VICENTINI, G. S., ROSSI, M. M. Entomofauna visitante na cultura da soja (Glycine max L. Merrill) var. Conquista. Montagem, Ribeirão Preto, v.7, n.7, p.47-53, 2003. SILVEIRA F. A., MELO G.A.R., ALMEIDA, E.A.B. Abelhas brasileiras: sistemática e identificação. Belo Horizonte, Ministério do Meio Ambiente, 2002
TOLEDO, V. A. A., MALERBO-SOUZA, D. T., SELEGATTO FILHO, J. C.,
A.
25 Pólen
PINTO,
S., RUVOLO-TAKASUSUKI, M.C.C., CHAMBÓ, E. D. Biodiversidade de agentes polinizadores e seu efeito na produção de grãos de soja, var. Mon Soy 3329. Revista Varia Scientia Agrárias, v.2, n.1, p.123-130, 2011
CANA-DE-AÇÚCAR: MANEJO DE PRAGAS DE VERÃO
Por Dr. Alexandre de Sene Pinto Sócio e Consultor em Manejo Inteligente de Pragas da Occasio, Piracicaba, SP Professor da Agronomia do Centro Universitário Moura Lacerda, Ribeirão Preto, SP
Acana-de-açúcar não consegue produzir no seu máximo potencial devido a diversos fatores, como o clima, mas as pragas e as doenças levam uma fatia importante dessa produtividade.
A cultura é atacada principalmente por pragas de solo e elas são controladas principalmente no outono e inverno. Não é a melhor das estratégias, pois nesse período o solo está seco e para os implementos colocarem o inseticida onde estão as pragas (cerca de 10 cm de profundidade) são necessários muitos cuidados técnicos ou medidas não operacionais.
Entretanto, no verão, todas essas pragas de solo têm seus adultos mais expostos na superfície do solo, para cópula ou dispersão, o que facilitaria muito o nosso trabalho de manejo.
É o caso do gorgulho-da-cana, Sphenophorus levis, espécie mais comum nos canaviais. Em agosto, os adultos começam a ser formados dentro dos internódios basais (erroneamente chamados de rizomas), principalmente abaixo da superfície do solo (até 8 cm). Nessa fase eles são amarelados e ficam debaixo do solo até que cerca de 70 mm de chuva se acumule em 7-10 dias para que eles
saiam desse ambiente. Na superfície do solo, os adultos escurecem e as fêmeas ainda levarão uns 30 dias para começarem a colocar seus ovos dentro das plantas, 1 a 2 por semana, durante seus 200 dias de longevidade (no final da vida elas não colocam mais ovos).

Essa é uma fase de vulnerabilidade de Sphenophorus e, hoje, os agricultores e corpo técnicos de Usinas e Destilarias têm realizado aplicações do fungo Beauveria bassiana até um mês da saída do solo e depois de dois meses. Uma terceira aplicação tem sido necessária somente em anos

26 No Campo
chuvosos do Paraná e Mato Grosso do Sul. Essa estratégia tem ajudado a diminuir infestações da praga. Outra estratégia é o preparo e distribuição de iscas tóxicas artificiais pelo canavial. As iscas nada mais são do que bagacilho de cana misturado a calda de cana fermentado, açúcar mascavo, uma substância ligante, como amido, xantana, e algum inseticida de ação rápida para Sphenophorus. Pequenas iscas são preparadas e distribuídas pelo drone com distribuidor de tubetes de Cotesia flavipes na proporção de 100 por hectare. As iscas duram o tempo que a substância ligante durar, e por isso ela é muito importante, ou até o fim da ação efetiva do inseticida.
No período chuvoso, o uso de nematoides entomopatogênicos dos gêneros Steinernema ou Heterorhabditis, recém-lançados no Brasil, deverá reduzir muito as populações de Sphenophorus em campo, assim como de todas as demais pragas de solo e broca-da-cana, Diatraea spp., dos baixeiros. Deverá ser uma fase importante!

As estratégias usadas para Sphenophorus servem para o besouro-rajado, Metamasius hemipterus, que começa a preocupar em todo o Brasil.
Migdolus e pães-de-galinha fazem suas revoadas no período chuvoso, ficando muito vulneráveis às nossas ações. Os machos de migdolus saem do solo nesse período e voam longas distâncias atrás de suas parceiras que não voam e não se dispersam muito. Estratégias de eliminação massal desses machos, com armadilhas de feromônio sexual sintético ou aplicação de inseticidas em faixas ou em barreiras em área total são muito importantes nesse momento.
Os pães-de-galinha, machos e fêmeas, são muito atraídos por luz e usar caixas d´água com uma lâmpada forte no centro dela, em beiradas de
rodovias e carreadores movimentados, ajuda a eliminar parte da população desses bonitos e indesejáveis insetos. Na caixa deve ser colocado água e detergente (pouco), para quebrar a tensão superficial da água e para que os insetos afundem, e ela deve ser vistoriada todas as semanas para retirada dos adultos e reposição ou troca da água. Uma a cada quilômetro tem se mostrado suficiente.
A broca-gigante tem seus adultos controlados nos períodos chuvosos e secos, mas no primeiro é onde ocorrem as principais revoadas. Localizados os refúgios de cópula, que ocorre entre 11h00 e 15h00 na maior parte do Brasil, o controle de adultos sempre é realizado na entrada do canavial que faz interface com esses locais. Para tanto, usam-se inseticidas de impacto e curto período residual. Essa estratégia, hoje, é a mais importante para o manejo dessa praga.
As demais pragas de solo, como broca-peluda, Hyponeuma taltula, elasmo, curculionídeos etc., não têm estratégias de controle bem definidas.
Acabam sendo afetadas pelos controles de outras pragas.
As grandes vilãs da primavera e do verão são a broca-da-cana e as cigarrinhas, como a cigarrinha-das-raízes Mahanarva spp. As duas estão entre as pragas-chave da cana-de-açúcar, das mais importantes, pelos prejuízos que causam.
A infestação mais severa que a broca-da-cana causa é logo no início das chuvas, onde posturas pequenas e imperceptíveis para os predadores e lagartas grandes localizadas nos primeiros entrenós em reinfestações, se desenvolvem e dão origem aos primeiros adultos que colocarão seus ovos em ambiente livre de predadores. Na seca, os inimigos naturais da broca têm suas populações severamente diminuídas e precisam de um certo tempo para se restabelecerem no ambiente. Nesse cenário, a broca-da-cana surge imponente e destruidora.
Todas as melhores estratégias, com ação rápida, devem ser usadas no início das chuvas. Quebrado o ciclo
27 No Campo
Adobestock
No Campo
da praga, os demais meses chuvosos sofrem menores pressões da broca. O uso de inseticidas do grupo das diamidas, como clorantraniliprole e flubendiamida, ou metoxifenozida + espinetoram, são excelentes opções químicas nesse momento. No campo dos biodefensivos, esse é o momento para Trichogramma galloi, uma pequena vespa que controla ovos da broca, em três a cinco liberações em semanas seguidas, via drone.
Esses produtos garantem 60 dias de ação no controle da broca-da-cana nesse período chuvoso. Uma nova ação será necessária logo após esse período. Normalmente se muda o grupo químico, mas se as diamidas tiverem um inseticida fisiológico adicionado a elas, como triflumurom, elas podem ser utilizadas novamente. Ou se repete metoxifenozida + espinetoram, que por ter dois grupos químicos diferentes na mistura não levaria a casos de resistência da praga. A vespinha Trichogramma pode ser usada em ações seguidas, pois macrobiológicos não estão associados a casos de resistência. Como mais opções biológicas, esse é um bom momento para se utilizar os fungos entomopatogênicos Beauveria bassiana ou Isaria fumosorosea, para o controle da broca, com ações ovicida e larvicida (e em pupas, no caso de Isaria).
Numa terceira intervenção, desde que já se tenha entrado num período menos chuvoso, pode-se começar a usar inseticidas “fisiológicos”, com período de ação de cerca de 30-45 dias, ou a tradicional vespinha Cotesia flavipes, que tem uma melhor performance nessa fase.
Aliás, Cotesia pode e deve ser usada o ano todo nos canaviais para diminuir a pressão da broca-da-cana, assim como os fungos Metarhizium anisopliae, Beauveria e Isaria
As cigarrinhas-das-raízes começa a ser controlada quando as primeiras ninfas surgem (21 dias após o acúmu-
lo de 70 mm de chuva em 7-10 dias) e quando atingem duas ninfas por metro. São vários os inseticidas químicos sintéticos que podem ser usados nesse momento, mas tiametoxam e imidacloprido devem ser evitados quando as infestações forem maiores do que 5 ninfas por metro, pois o período de ação deles cai muito.
Sempre deve ser incluído o fungo Metarhizium anisopliae nas aplicações de inseticidas no controle das cigarrinhas, mesmo que a dose do inseticida tenha que ser reduzida em 10% para viabilizar a ação. Muitos dos inseticidas químicos têm ação maior sobre ninfas grandes e falham um pouco no controle das pequenas, mas Metarhizium controla mais ninfas pequenas. Além disso, o fungo cria um segundo modo de ação à mistura e tem a chance de aumentar o período de ação do conjunto, visto que ele persiste no campo, e tem ação secundária de controle sobre outras pragas, como broca-da-cana, Sphenophorus e pão-de-galinha.
A cana-bisada precisa ter broca-da-cana e cigarrinhas, principalmente, manejados, até que o início da co-
lheita chegue. Um canavial bisado aumenta muito as pragas ao redor dele e isso acaba por comprometer todo o manejo. Nesse caso, a liberação de Trichogramma ou Cotesia ao redor do canavial, a cada dois meses, ajuda demais! E a aplicação aérea de Metarhizium + Beauveria é uma estratégia que mantem cigarrinhas e demais pragas sob pressão negativa, ajudando na redução populacional.
Um bom controle de plantas daninhas, especialmente das gramíneas, também colabora com o controle de pragas. Um canavial com as entradas repletas de gramíneas tem a infestação final da broca aumentada em até 1%, o que pode prejudicar demais um bom trabalho realizado no manejo dessa praga.
São muitas opções, mas todas elas precisam ser tecnicamente empregadas, não importando se são biodefensivos ou defensivos químicos, pois ambos são muito técnicos. O que não pode é relaxar no manejo de pragas de verão, para que o inverno não seja tenebroso e o próximo verão mais trabalhoso!

28
Campo Gravena
O MEP–MANEJO ECOLÓGICO DE PRAGAS NO AGRONEGÓCIO DE ALGODÃO
 Por Santin Gravena Pesquisa Consultoria e Treinamento em MEP, Jaboticabal, SP
Por Santin Gravena Pesquisa Consultoria e Treinamento em MEP, Jaboticabal, SP
Embora estejamos afastados dos campos do algodão desde o início dos anos 80 do século passado, a cultura nos empolga quando pensamos em passar do MIP para o MEP, com as táticas modernas que temos hoje, que naquela época eram consideradas utópicas. Uma delas é a realidade dos microbiodefensivos se multiplicando no mercado fitossanitário brasileiro, representado pelos fungos, bacterias e virus formulados por diversas empresas especializadas que podem ser aplicados por pulveri-
vos, produtos estes que são insetos ou ácaros classificados como predadores ou parasitóides que podem ser liberados nas plantações com o auxilio maravilhoso dos drones agrícolas. Só essas duas categorias de táticas de manejo caracterizam a mudança de consideração de um simples MIP para um complexo MEP – Manejo Ecológico de Pragas e Doenças. Some-se a essas duas citadas, os insumos já consagrados para algumas doenças como os produtos à base de Trichoderma e Bacillus subtilis,
sando melhoria biológica dos solos que reflete no fortalecimento das plantas contra pragas através do sistema radicular mais sadio e vigoroso. Enquanto isso, cabe-nos resgatar os Inspetores de pragas também nos campos de algodão para que os produtores tenham uma visão contínua de seus campos de produção para se apresentarem aos chamados dos programas globais de sequestro de carbono ou dos ESG. Para isso, vamos
29
Adobestock
Campo Gravena
Princípios do MEP e Suas Interfaces
1. Inimigos Naturais e Controle Biológico. Na cultura algodoeira atual temos que considerar duas situações básicas: Algodão não-Bt e Algodao Bt, segundo escolha do produtor. Estimativas dão conta de que são muito poucos os que optam por não-Bt. Portanto, o MEP é muito importante ser adotado na zona de refúgio das variedades de Algodão-Bt que tem que ser 20% da área total e uma zona a cada 800m de distância máxima. O problema é qe os produtores ainda estão muito resistentes ao uso da área de refúgio alegando custo, improdutivo e difícil de cuidar. Neste artigo, nós vamos abordar os inimigos naturais e o controle biológico que eles exercem na cultura do algodão, tanto na zona de refúgio como na área principal. Neste princípio estão envolvidos diretamente os outros 3 a seguir na forma de preservação e aumento de inimigos naturais.
2. Monitoramento, amostragem, níveis-de-ação e níveis-de-não-ação. Somente com a presença do Inspetor de Pragas é que poderemos utilizar os inimigos naturais chaves para aplicar o nível-de-não-ação. Esse indicador é mais uma caracterisstica que qualifica o MEP no lugar do MIP.
3. Seletividade, Aplicação Seletiva e Manejo de Resistência das Pragas. A escolha de produtos mais seletivos fisiologicamente é muito importante embora difícil. Aplicação seletiva de produtos não seletivos fisiologicamente, é mais viável. Mas, o manejo de resistência tanto da área principal que é OGM Bt para as outras pragas exceto as lagartas, é imprescindível utilizar a zona de refúgio para evitar a resistência das lagartas à variedade transgênica Bt, que hoje em dia ocupa 99% das lavouras brasileiras de algodão.
4. Manejo ambiental de pragas. Adotar principalmente o “vazio fitossanitário”, ou seja, destruição de restos culturais, tiguera que é excelente para criar bicudo na en-
tre-safra, adotar a cultura isca de 15 m e o uso do tubo mata-bicudo. Se possível ao implantar a cultura principal, deixar uma área natural, pois não recebendo inseticidas e outros produtos, serve de abrigo para sobrevivência e reprodução de inimigos naturais os quais vamos abordar a seguir.

30
Adobestock
Resultados de Estudos Realizados

Em 1982 deslocamos para o Texas, USA, aceito pelo Professor Winfield L. Sterling da Texas A&M University, em College Station, como Orientador Anfitrião, sabendo que o foco
Campo Gravena
de sua pesquisa era o estudo dos artrópodos predadores de pragas do algodão. O inusitado deste estudo foi o uso de radioatividade pelo (fósforo)32P para comprovar que aquele inseto ou aranha é realmente predador daquela praga estudada. Havia já uma técnica desenvolvida de injeção do 32P em outras espécies em fêmeas e que era nossa incumbência injetar na praga chave Curuquerê do Algodoeiro, Alabama argillacea, que tinha em estoque no laboratório de controle biológico do Prof. Sterling. O estudo foi realizado na plantação
da área agrícola da Prisão do Texas situada Elis Unit, Texas Department of Corrections, Huntsville, cerca de 100 km longe de College Station, TX, onde era possível porque não era utilizado qualquer pulverização de inseticida. Estudos complementares foram feitos em Laboratório também, em College Station. Basicamente era obtenção de ovos radioativos ovipositados pelas mariposas injetadas com 32P e destes obtenção de larvas de primeiro etágio radioativas para serem capturados e consumidos pelos predadores. Do início de exposição
31
Campo Gravena
de ovos e de larvas nas gaiolas de tela fina, 24 e 48 horas depois, a avaliação era feita usando-se um contador geiger (Beckman Low Beta/matic II scintillation counter). A medição de radioatividade era feita em dpm (disintegration per minuite). Dois destaques percebemos neste trabalho: as operárias da formiga Solenopsis invicta só carregam os ovos do curuquerê, com raioatividade média de 0,017 dpm. Os alados predam mais por necessidade maior de proteina, acumulando 8,8 dpm e a rainha que só recebe os ovos carregados pelas operárias, 60,0 dpm; os predadores mastigadores tendem a apresentarem mais radioatividade do que sugadores, pois estes deixam a carcaça e os mastigadores consomem tudo. As taxas de Eficiência de Predação Natural, por esse estudo, foram de 88,7 e 88,4% para ovos e larvas do curuquere, respectivamente.
Voltando para o Brasil, fizemos com os estudantes de agronomia orientados na Unesp de Jaboticabal, vários outros trabalhos baseados neste, porém sem o uso de radioatividade, confirmando a utilidade dos predadores no MEP-Algodão. Alguns deles foram incluidos em protocolos que viram fichas de inspeção que servem para a aplicação do Nível de Não-Ação que caracteriza o MEP. Estes que são considerados na amostragem, são classificados de chaves porque predam pragas chaves, como o Bicudo
Anthonomus grandis, Curuquerê A. argillacea, lagarta da maçã H. virescens, H. armigera, Spodoptera frugiperda, etc., Ácaro Branco Polyphagotrasonemus latus, Ácaro Rajado
Tetranychus urticae, Mosca Branca
Bemisia tabaci, Pulgão do Algodão
Aphis gossyipii, etc. O conhecimento dos artrópodos benéficos predadores no que se refere à importância na atuação no controle biológico natural da cultura algodoeira é fundamental para as 3 partes que compõe ou deveria compor uma plantação nos dias de hoje que quase 100% é da variedade transgência Bt: plantação

principal + cultura isca + zona de refúgio. Portanto, é hora do produtor adotar o sistema de MEP nessas partes distintas focando a preservação inimigos naturais que veremos a seguir, através de produtos seletivos, manejo ambiental rigoroso no vazio sanitário, aumento de inimigos naturais através de faixas de culturas atrativas auxiliares de inimigos naturais como sorgo granífero e girassol, uso dos níveis-de-não-ação, uso dos micro e macrobiodefensivos.
1. Orius tristicolor e O. insidiosus (Hemiptera: Anthocoridae). É um percevejinho medindo cerca de 3 mm e contorno oval. Coloração geral branco e preto. As fêmeas põem os ovos internamente no tecido foliar e o ciclo de vida de ovo a adulto é de 20 dias. Ele se reproduz em várias gerações numa só safra agrícola. Em condições normais de uma lavoura de algodão a pesquisa tem mostrado que este predador migra para a cultura do algodão para predar ovos, larvas recém nascidas de lagartas em geral, ácaros e seus ovos, tripes, pulgões, mosca branca. Em geral um adulto preda 1 ovo de lagarta da maçã Heliothis virescens ou Helicoverpa armigera ou uma lagarta de 1º. instar dessas espécies a cada 2 dias. A População de Orius numa plantação de algodão pode ter em média 3/metro de rua, mas pode chegar 5 a 10 durante a safra. Além do algodão, são muito comuns em sorgo granífero, milho em busca de pólem como alterantiva, tomate e soja.
2. Geocoris punctipes e G. pallens (Hemiptera: Geocoridae). É o Percevejo de Olhos Grandes, medindo 3,6 mm e como o próprio nome sugere vive sobre o solo. Sobe constantemente para as plantas como na foto à caça de presas até o seu tamanho que são preferencialmente ovos, larvas de lepidopteros de 1º. Estágio, ácaros e seus ovos, moscas brancas, etc. Os ovos são alongados e claros, depositados isoladamente ou em grupos, nas folhas próximas às presas em potencial. O ciclo biológico é de 30 dias de ovo a adulto. Ninfas e adultos são predadores, mas podem sobreviver com néctar e pólem quando as presas são escassas. Seus aparelhos bucais são perfurantes e atacam suas presas sugando os conteúdos da hemolinfa. G. punctipes segundo Lingren e colaboradores em 1968, pode consumir 1,9 ovos e 1,4 larvas de 1º. Instar de H. virescens em ponteiros de algodão por dia, equivalendo a eficiência de 78 a 94% de controle, respectivamente. Estas taxas, contudo foram um pouco maiores quando se utilizou 32P no Texas. E nos nossos estudos com Alabama argillacea conforme já citado, o consumo foi de 2,0 ovos e 1 larva de 1º. Instar/dia. Estudos mostraram que as ninfas podem consumir até 1.600 ácaros antes de atingir a idade adulta, enquanto os adultos consomem até 80 ácaros por dia. Observações dão conta de que esses percevejos de olhos grandes são predadores efetivos de ovos de Lagarta Rosada do Algodoeiro Pectinophora gossypiella

32
(Hemiptera: Nabidae). Ultimamente não temos encontrado facilmente esse predador nas lavouras. É um percevejinho que juntamente com os dois anteriores formam o trio de predadores chaves das pragas do algodão principalmente das lagartas em geral. Este é alongado, de cor pálida a marrom claro, exibindo fêmur forte para reter as presas e medindo cerca de 10 mm de comprimento (foto) e estreito na largura. Vivem de 3 a 8 dias, a fêmea bota em média 112 ovos de forma isolada, que são alongados, branco-cremoso no início e amarelo no final. O ciclo de ovo a adulto é de 31,6 dias em média. Usando 32P no Texas em 1982, encontramos que N. capsiformis consome 3 ovos de A. argillacea por dia e estudo de Winfield Sterling em 1983 concluiu que a densidade média é de 1-2 por 10 m de rua podendo chegar até a 10/m de rua. As culturas mais frequentadas por N. capsiformis são milho, sorgo alfafa, feijão e tomate, além do algodão.


Campo Gravena
da cultura do pêssego. Em 2002, foi detectado pela primeira vez em Curitiba, no Paraná, Brasil, provavelmente introduzido acidentalmente. Seu tamanho varia de 5,5 a 8,5 mm de comprimento. As diferentes formas e cores são: a comum, 1. “succinea”, cor laranja ou vermelha com 0 a 22 manchas pretas de tamanho variável; a 2. “conspicua”; e a 3. “spectabilis”, são uniformemente pretas com, respectivamente, duas ou quatro manchas vermelhas. O pronoto (“pescoço”) é branco com uma mancha preta, formando uma M e quase inteiramente preto. A parte de baixo é escura com uma ampla borda marrom-avermelhada. A forma do ovo é oval, moderadamente achatada, com um comprimento de 1,2 mm. Após a postura, sua cor muda de amarelo pálido para amarelo escuro e, 24 horas antes da eclosão, a cor do ovo muda para um cinza escuro. No estudo do Texas encontramos por radioatividade somente uma larva de Coccinellidae, que consumiu 1,74 ovos por predador por dia. Agrega valor no consumo real realizado pelos 3 percevejos anteriores, comprovados existirem numa plantação de algodão pelo 32P. Percebe-se que após a entrada desta espécie ela tomou lugar (nicho ecológico) das outras semelhantes, como Cycloneda sanguinea, Eriopis conexa, Hippodamia convergens, Olla abdominalis, Colleomegilla maculata, etc.
aranhas mais frequentes e predadoras de pragas na cultura algodoeiras nas condições brasileiras. Misumenops é conhecida como Aranha Carangueja porque tem os 3 pares de pernas alongadas na forma de um caranguejo como se fosse abraçar a presa e também é lembrada sempre como a aranha da flor onde é mais encontrada, mas ela patrulha toda a planta onde habita. O sorgo granífero é ótimo para atração de aranhas para passar para o algodão e pesquisa indica Caçadora Cheiracanthium inclusum (Blackwall) e a caçadora carangueja, Misumenops pallidus (Keys.), foram consideradas duas das mais abundantes. As variedades de sorgo granífero variam na atratividade de insetos benéfico, mas todos são atrativos. Nos estudos do Texas com 32P concluímos que Misumenops sp. ataca e devora 2 larvas de Curuquerê de primeiro instar por dia. Um pesquisador do Arizona revelou que a vegetação ao redor da plantação do algodão é importante para manter a população de aranhas do gênero Misumenops e no Brasil, nossas pesquisas demonstraram também que esse gênero de aranha é o mais populoso nos campos de algodão brasileiro.
4. Harmonia axiridis (Coleoptera: Coccinellidae). No final da década de 1990, H. axyridis foi introduzido pela primeira vez em Mendoza, Argentina, para controlar pulgões

5. Aranhas Predadoras Misumenops spp. (Thomisidae) & Cheiracanthium inclusum (Cheiracanthiidae) Theridula gonygaster (Theridiidae) Chrysso clementinae (Theridiidae). Essas são as
6. Formigas (Hymenoptera: Formicidae) Pheidole sp. e Solenopsis invicta. Estes dois gêneros representam os dois grupos de predadores dos mais importantes que cohabitam os campos de algodão se não são destruidos pelo homem. As dietas deles são fundamentalmente insetos. Com as chuvas os seus ninhos sofrem por que as águas os destroem. Devido a isso só os vemos facilmente no

33
3. Nabis capsiformis
Campo Gravena
período do outono inverno que não chove tanto. Quando o agro planta soja, milho ou algodão essas formigas já se preparam para caçar as lagartas e outros insetos que abordam a cultura para reprodução. São os predadores invisíveis, mas que prestam um grande serviço ao pessoal do Agro, controlando as pragas. As operárias trabalham incansavelmente na caça de ovos e larvas de qualquer tamanho das lagartas de Heliothis, Helicoverpa, Alabama, Spodoptera e Anthonomus grandis, pragas do algodão em geral. Pheidole tem uma rainha e duas castas de operárias (1 maior e 1 menor). Os ninhos são aqueles buracos discretos que geralmente estão sob a copa do algodoeiro, ou da soja e as operárias caçadoras saem do ninho subindo já direto para as plantas em busca das presas. Já Solenopsis constrói aqueles ninhos de terra solta nas proximidades das plantações e fazer carreiros semi-subterrâneos em direção às plantações para buscarem as presas. Ambas as formigas buscam presas para amimentarem as rainhas e as proles nos ninhos. Quando expomos ovos e larvas radioativas no algodão, Texas, USA, verificamos que as operárias apresentam baixa radioatividade.
É que elas apenas carregavam as presas (ovos e larvas), mas ao medirmos uma rainha, a radioatividade foi superior aos outros insetos porque ela era speralimentada pelas operárias que cuidavam dela. Pelos estudos do Prof. Sterling, em 1979, no Texas, Solenopsis era o predador chave do bicudo, consumindo 85% de suas larvas. As operárias mediram 0 a 3 dpm e a rainha 60,0 dpm e duas fêmeas aladas estavam com 8,8 e 7,8 dpm. Uma formiga Solenopsis foi coletada e constatada que consumiu 3,7 larvas em 24h. A proporção de predação na relação inseto:aranha, de ovos entre insetos e aranhas foi de 7:4 e de larva foi de 2:7. Nos Estudos que fizemos no Brasil depois do Texas demonastraram que Pheiodole sp. é cerca de 300 vezes mais abundante nos campos de algodão do que Solenopsis invicta. Isso se deve talvez a situação dos ninhos: solenopsis fora da plantação e pheidole dentro.
Estes são os Inimigos Naturais Chaves que poderiam estar nas fichas de inspeção ou tablets de automação para o uso de níveis-de-não-ação. Existem outros como o crisopídeo bicho lixeiro Ceraeochrysa cubana,
que atuam como predador generalista e os adultos imigram das áreas naturais ou outras culturas parar as 3 áreas do algodão: Principal, cultura isca e refúgio. O ácaro predador Phytoseiidae que pode ser útil ser mantido para predação dos ácaros rajado e branco. A tesourinha Doru luteipes que preda lagartas. Os percevejos mirídeos e muitos outros predadores e parasitoide (Trichogramma sp., parasitoide de ovos) como o Lysiphlebus testaceipes dos pulgões. Para aumento dos inimigos naturais temos o Trichogramma, o ácaro predador, o crisopídeo (Chrysoperla externa), os fungos metarhizium, beauveria e isaria e o vírus baculovirus que já são encontrados em produtos comerciais fornecidos por biofábricas para serem aplicados nos algodoais por meio de drones. Assim, essa abordagem pretende auxiliar quem gostaria de estar adotando o MEP em uma lavoura de algodão estando com o pensamento voltado para as exigências cada vez mais crescentes a nível mundial no sentido de só comercializar produtos agrícolas oriundos de produções auto-sustentáveis ecologicamente.

34
Adobestock
A revolução da agricultura
Nova safra, novas escolhas, novos ganhos.
O manejo biológico é a principal estratégia para obter maior produtividade, maior rentabilidade e perenidade no sistema de produção. Manter o equilíbrio do sistema solo-planta com uma combinação de microrganismos ajuda a revitalizar o solo, proteger de pragas e doenças, ativar a estrtutura da planta, potencializar o crescimento e proteger de grandes variações do clima.



A revolução da agricultura já começou!
Conheça o melhor do biológico para a sua lavoura.
agrivallebrasil
Parra Fala

O CONHECIMENTO DO NÍVEL DE CONTROLE DE PRAGAS É FUNDAMENTAL PARA A LIBERAÇÃO DE INIMIGOS NATURAIS
No Brasil cresce, de forma impressionante, a utilização do controle biológico, seja com micro ou macrorganismos. É um aumento anual de 30-35% em relação aos 1015% no mundo.

Os desafios que eram relatados há até pouco tempo, são, nos últimos anos, transpostos de forma rápida e, dentre eles, destaca-se a utilização de drones para a liberação de macrorganismos. Aumentou tanto a utilização destes drones que hoje o Brasil exporta a tecnologia para outros países.
Por outro lado, continua a se incentivar, cada vez mais, a utilização do controle biológico dentro de Programas de Manejo Integrado de Pragas (MIP).
Portanto, embora ainda não seja muito grande a utilização de MIP no Brasil em relação a países como Austrália, por exemplo, devem ser obedecidos os preceitos desta tecnologia dentro do controle biológico.
Assim, para a liberação de inimigos naturais seja manualmente ou de forma aérea ou em qualquer tecnologia, a liberação deve ser compatível com a população de pragas existente na área.
É óbvio que se se tratar de um parasitoide de ovos tem que haver ovos da praga na área a ser tratada, bem
como tem que haver larvas, ninfas, pupas ou adultos se forem parasitoides destas respectivas fases do inseto.
A diferença entre agroquímicos e parasitoides (ou predadores) é que a liberação deve ser feita um pouco antes, pois os inimigos naturais não têm um efeito de choque tão gran-
de como os químicos (um piretroide, por exemplo).
Assim, o agricultor deve estar atento à época de liberação com drones, para que não ocorram insucessos que podem prejudicar a imagem desta excelente tecnologia. Nos EUA existem regiões em que se comenta
36
Por Dr. José Roberto Postali Parra Departamento de Entomologia e Acarologia, ESALQ/USP, Piracicaba, SP
Adobestock
Parra Fala
que se faz a liberação de forma preventiva por meio de drones, como se fosse um calendário, muito utilizado para químicos.
As amostragens para determinação populacional das pragas podem ser feitas por contagem direta, com aparelhos que exigem a presença do operador (rede entomológica, pano de batida), com aparelhos que não exigem a presença do operador, sem atraentes ou com atraente, caso das armadilhas adesivas, bandejas d´água (para pulgões), armadilhas luminosas, iscas, frascos caça-moscas e feromônio sexual.

Hoje, sensoriamentos remotos (reflectância, laser) são métodos que estão sendo aperfeiçoados para chegar ao agricultor.
Como tem sido constantemente referido, o Brasil tem uma agricultura característica para a utilização do controle biológico, desde que as grandes áreas, muitas vezes, inviabilizam muitas das amostragens.

Os feromônios sintéticos têm sido
utilizados em alguns países e, no Brasil, o Ferocitrus Furão®, resgistrado pata o bicho-furão (Gymnandrosoma aurantianum), dá uma indicação de como liberar o parasitoide Trichogramma atopovirilia com base na coleta em armadilhas de 6-8 indivíduos e baseando-se nesta coleta,
recomendar a liberação 5 dias depois (antes que a larva penetre no fruto) (Tese de Lucas V. Cantori, no prelo).
Em cana-de-açúcar, onde se libera Trichogramma galloi em 3-4 milhões de hectares para controlar Diatraea saccharalis, a broca-da-cana, como não se dispõe do feromônio sintético
37
Adobestock
Parra Fala
para essa praga, usam-se pupas fêmeas (4 por armadilha do tipo Delta) em 12,5 hectares para avaliar quando se faz a liberação, após a coleta de machos atraídos pelas fêmeas que emergiram. Quando forem encontrados 10 machos de D. saccharalis por armadilha liberam-se, em 5-10 dias depois, T. galloi na área infestada, repetindo-se a liberação de 50.000 parasitoides por hectare por mais duas vezes, a intervalos semanais.
Por outro lado, algumas amostragens já estão consagradas, como para a broca-do-café (Hypothenemus hampei) (5% de frutos atacados); para lagartas da soja (20 lagartas por metro linear, exceto para Heliothinae e complexo Spodoptera – método do pano de batida); broca-da-cana (3-5% das plantas com broca “fora”).
Para o controle biológico, a fenologia da planta, como referencial para a liberação seria muito interessante:
• Cana-de-açúcar: as primeiras posturas de D. saccharalis ocorrem com 40-50 dias depois do plantio de algumas variedades de cana, época em que se deve iniciar o controle com T. galloi;
• Soja: as liberações do parasitoide de ovos Telenomus podisi para o controle de Euschistus heros, o percevejo-marrom da soja, devem ser feitas antes do florescimento;
• Milho: para o controle de Spodoptera frugiperda, as liberações de Trichogramma pretiosum devem ser iniciadas até 20 dias após a semeadura.

O zoneamento de pragas e inimigos naturais como para Diaphorina citri e Tamarixia radiata, respectivamente, podem indicar a época de liberação, baseando-se em exigências térmicas e higrométricas, pois nestes dados podem ser feitas as liberações nas épocas em que ambos coexistam e tenham brotações, para a postura da praga. Já existem tais zoneamentos com aplicativos para tal.
Portanto, as exigências térmicas e hi-
grométricas poderão também ajudar na previsão de ocorrência e evolução das pragas.
De qualquer forma, fica evidente a necessidade de se conhecer, a fundo, a biologia da praga e do inimigo natural para prever a melhor época de liberação.
Estações de aviso regionais poderão, no futuro, auxiliar o agricultor na tomada de decisão para liberação de inimigos naturais. Muitas vezes, o número de uma praga amostrada indica a necessidade de controle, mas
a umidade relativa do ar no período é muito baixa e o inseto não coloca ovos (caso do bicho-furão). Assim, se houver aplicação do inimigo natural será perda de tempo e aumento de gastos. Assim, a biologia da praga e do inimigo natural devem balizar todas as tomadas de decisão de liberação de inimigos naturais.
Para finalizar, muitas vezes os resultados são inadequados não devido à técnica de liberação utilizada, mas sim devido ao momento errado da liberação.

38
Adobestock
Adobestock



Revista de Controle Biológico











































 Por Santin Gravena Pesquisa Consultoria e Treinamento em MEP, Jaboticabal, SP
Por Santin Gravena Pesquisa Consultoria e Treinamento em MEP, Jaboticabal, SP